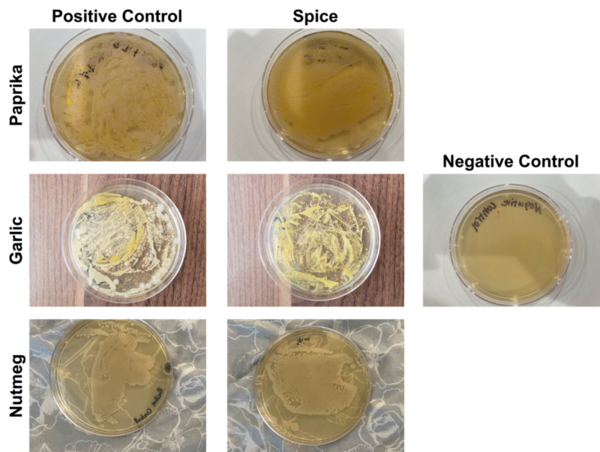
Testing antimicrobial properties of common household spices in a real-world scenario

In this study the authors look at elastic modulus and stiffness of steel rules with vary lengths of cracks. They found that cracks decreased the overall elastic modulus and bending stiffness of the ruler. This work has applications to structural engineering and the design of items such as airplanes and bridges.
Read More...